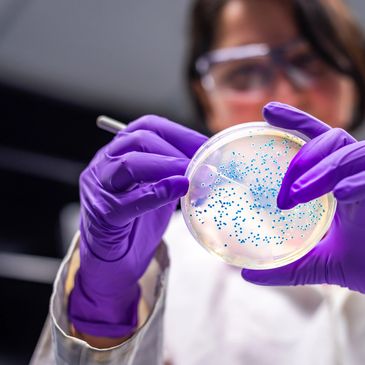

Our Impact
Fund Groundbreaking Research: Investing in innovative scientific studies that aim to understand, detect, and ultimately eradicate pancreatic cancer and other forms of the disease.

Provide Patient and Family Support: Offering resources, guidance, and emotional assistance to those navigating the complex journey of cancer treatment and recovery. This includes financial aid, access to support groups, and information on coping strategies.

Advocate for Improved Care: Collaborating with healthcare providers and policymakers to ensure that patients receive the highest quality of care and have access to the latest treatments.
Copyright © 2025 John and Pat Tarantino Charitable Foundation - All Rights Reserved.
This website uses cookies.
We use cookies to analyze website traffic and optimize your website experience. By accepting our use of cookies, your data will be aggregated with all other user data.